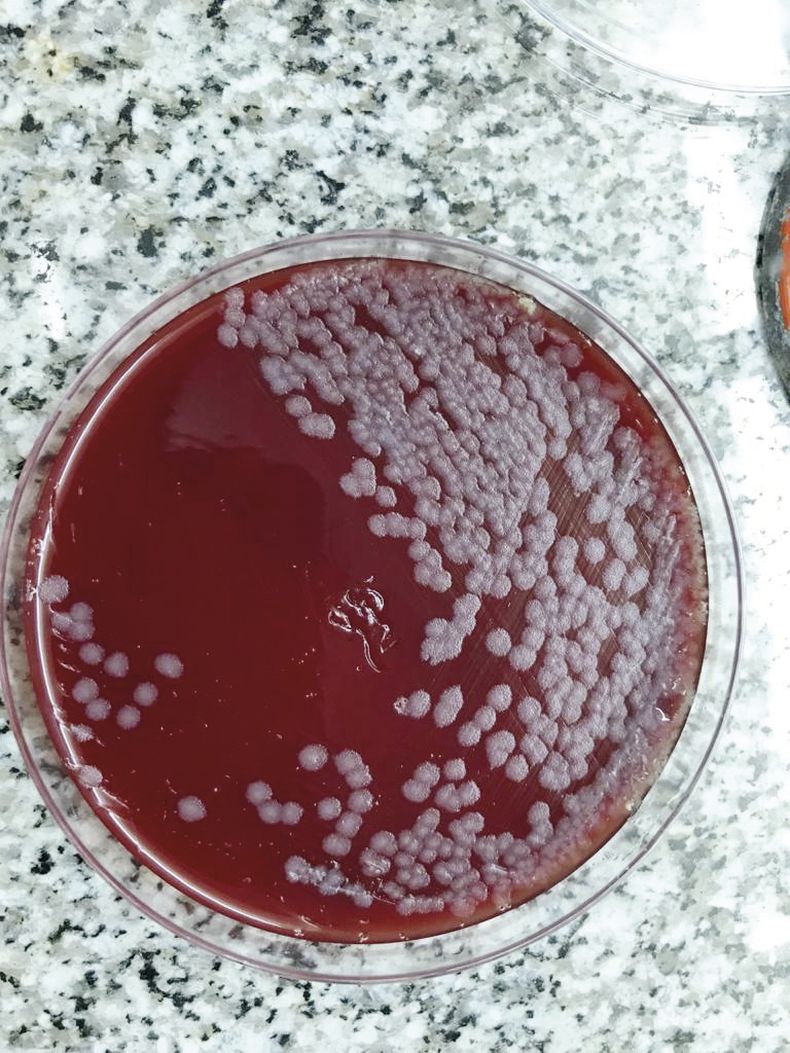
Carbunclo 2.jpg

Hace unas semanas, el Colegio de Veterinarios de La Pampa encendió la alarma sobre la mortalidad de animales en un campo de Unanue: 30 animales muertos por carbunclo. Los veterinarios se miraron y casi que se los pudo escuchar: ¿la historia se repite? ¿Otra vez la vacunación contra la enfermedad había sido desestimada?
La vacuna contra el carbunclo es una de las más baratas dentro del sistema de producción de Argentina y tiene alta efectividad. Data del año 1886 y Pasteur donó sus primeras vacunas de carbunclo, fabricada en Francia, a la Argentina para que se aplique.
Si, fuimos el primer país fuera de Francia en tenerla y, actualmente tiene un costo de entre $140 y $150 por animal. ¿Y entonces? ¿Por qué no se vacuna?
MOTIVAR entrevistó a los referentes de la temática para intentar dar respuestas a estas preguntas que siguen apareciendo una y otra vez cada vez que sale a la luz un nuevo caso.
Es casi un hecho que la mayoría de los productores no vacunan Es casi un hecho que la mayoría de los productores no vacunan
Ramón Noseda, ex Laboratorio Azul y referente de la OMSA en esta zoonosis, resalta casi de forma diaria la importancia de vacunar no solamente en los lugares donde hay antecedentes de carbunclo sino en todo el territorio.
Casi en un pedido desesperado, el profesional insiste en que, por lo menos cuando aparece una muerte súbita y se descubre sangre por las aberturas naturales de los animales, se debe cortar un hueso largo y mandarlo al laboratorio para hacer el diagnóstico.
Carbunclo 2.jpg
El brote de carbunclo en Unanue se confirmó en Laboratorio Santa Rosa, de La Pampa.
"No importa si parece otra enfermedad, si los días previos hizo mucho calor, casi que no importa nada, sino que la única respuesta es el diagnóstico certero de que no se está frente a una enfermedad zoonótica, que se puede prevenir, a bajo costo y con alta eficacia", nos decía el veterinario.
Y agregaba: “Una vez que sabemos que estamos en presencia del Bacillus, hay que vacunar. Una vez por año, en caso de no tener antecedentes, y en caso de que el campo tuviera casos recientes, habría que hacerlo por lo menos de 2 a 3 veces por año durante los primeros 3 años”.
Respecto a la categoría de bovinos, es casi para todos, a partir de que el animal comienza a comer pasto.
Pareciera que la gente nunca va a tener el problema del carbunclo, hasta que lo tiene Pareciera que la gente nunca va a tener el problema del carbunclo, hasta que lo tiene
¿Por qué? Porque esta enfermedad deja esporas que se alojan en el ambiente y justamente eso es lo que ingiere el animal. Por eso se dice que el ternerito que aún no está destetado es el único que no debería ser vacunado.
Sin embargo y ante la insistencia de los veterinarios, es casi un hecho que la mayoría de los productores no vacunan.
El MV Luis Roberto Pérez, director técnico del Laboratorio Santa Rosa, y la MV Maria Belén Aab, de la misma empresa, fueron quienes recibieron las muestras del caso de Unanue. Y con ellos hablamos.
“En este caso puntual, junto con la veterinaria que asistió al campo en cuestión, fue una de las enfermedades que primero quisimos descartar", nos contó Pérez.
Y agregó: "Sin embargo, se suele pensar siempre primero en otras enfermedades; pareciera que la gente nunca va a tener el problema del carbunclo, hasta que lo tiene. Eso sí, desde ese momento, vacunan cada 6 meses; pero hasta que no se le muere un animal, ni se percatan”.
Descargate la versión completa de Motivar de Marzo/Abril y enterate cómo sigue la batalla contra el carbunclo.